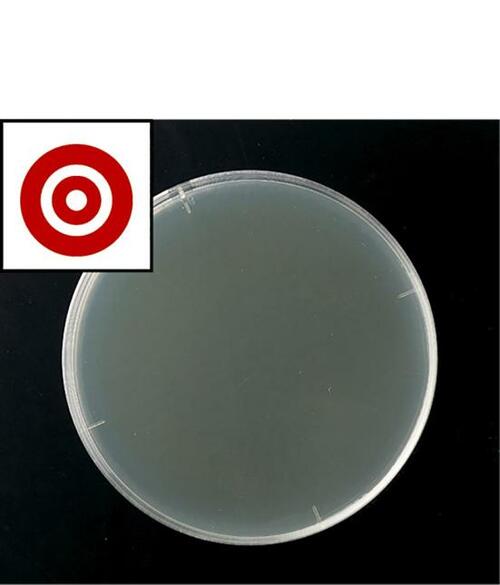
コスパの良さはNO.2！ピュアソン「ジアのチカラ」 イメージ2

今備えるべき最低限の防災用品を紹介

いつ「首都直下型地震」がいつ起きてもおかしくないと言われていますが、災害への備えはできていますか?
新型コロナウイルスの感染症リスクという新たなハードルができた今、コロナ以前とは災害への備え方が変わってきています。
今回、テストするモノ批評誌『MONOQLO』では、災害や医療のプロに取材を依頼して検証。その結果からわかった今備えるべき最低限の防災用品をご紹介します。
自宅待機で備える!コロナ時代の災害対応策とは?

コロナ時代に災害が発生した場合、倒壊の恐れがある住宅であったり、火災や浸水が想定されるエリアに住んでいない限り自宅で待機することが望ましいです。
その理由としては、
・避難所で感染症にかかるリスクがある
・そもそも避難所のキャパが減っている
などが挙げられます。

国際災害レスキューナースの辻さんによれば、避難所では3密対策として定員を大幅に減らしているとのこと。沖縄・奄美地方などを襲った2020年の台風10号では、「行ったけど入れなかった」とびしょ濡れで立ち尽くす人が続出したそうです。
そのため、コロナ以前とは違い、今では待機できるように家自体を強化したり、自宅からなるべく出なくて済むように備えておくことが必要になります。
そこで今回は、被災時に自宅を守るアイテムをピックアップ。地震や豪雨で被災して荒れた部屋を片付けるときに使える消毒剤をご紹介します。
※価格は検証当時から変わっている場合があります。
コスパがいい!オーヤラックス「ピューラックス」
オーヤラックス
ピューラックス
実勢価格:2560円
内容量:5L
※楽天のリンクは600mlの商品です
▼テスト結果
殺菌力:◎
コスパ:◎(512円/L)
災害の備えとしては、転倒防止など発災時の危険を防ぐグッズが注目されがちですが、被災後の復旧への備えも大切になります。
自宅待機となる場合は特に、汚物や雑菌の除去が必要になるため、業務用消毒剤を備えておくと安心です。「大雨などでは家屋の損傷自体は少ないものの汚れがひどかった」という被災者の声もありました。
オーヤラックス「ピューラックス」は、次亜塩素ナトリウムが成分の消毒剤。今回検証した中でも殺菌力が高くコスパがいいのでおすすめです。

黄色ブドウ球菌を殺菌できました!
ノロウイルスなどの感染症やO157などの食中毒の対策にも有効とされ、医療現場や飲食店でも使われています。また、厚生労働省は次亜塩素酸ナトリウム水溶液も新型コロナウイルスの消毒や除菌に効果があるという見解を示しています。災害用としてだけでなく、家庭でもさまざまな場面で活用することができます。
コスパの良さはNO.2!ピュアソン「ジアのチカラ」

ピュアソン
ジアのチカラ
実勢価格:2401円
▼テスト結果
殺菌力:◎
コスパ:○(600.25円/L)
ピュアソン「ジアのチカラ」は次亜塩素酸除菌水が成分の消毒剤。1Lあたり600円台で、ベストに次ぐコスパのよさでした。
殺菌力も◎です。
価格がちょっと高め……サラヤ「アルコール製剤」

サラヤ
アルコール製剤 SMART SAN アルペットLN
実勢価格:4700円
▼テスト結果
殺菌力:◎
コスパ:△(940円/L)
サラヤ「アルコール製剤 SMART SAN アルペットLN」は、価格がベストより一回り上でした。

黄色ブドウ球菌はほとんど繁殖していません。殺菌力は高いと言えます。
高価なのがネック……シーバイエス「サニッシュ」

シーバイエス
アルコール製剤 サニッシュ
実勢価格:5960円
▼テスト結果
殺菌力:◎
コスパ:△(1192円/L)
シーバイエス「アルコール製剤 サニッシュ」は、1Lあたり1000円超え。4製品の中で一番高価格でした。

こちらも殺菌力は高いです。
以上、消毒剤4選のご紹介でした。
災害そのものへの備えはできていても、被災後の備えまでは思いつかなかった……という方も多いのではないでしょうか。
今回紹介した消毒剤は、次亜塩素酸ナトリウムや次亜塩素酸除菌水、アルコール製剤などさまざまなものでしたが、テストした黄色ブドウ球菌に対する殺菌力は大差はありませんでした。家庭用として備えるならコスパがいいのはオーヤラックス「ピューラックス」がおすすめです。参考にしてみてくださいね。




自宅待機の備えがこれまで以上に大事です。